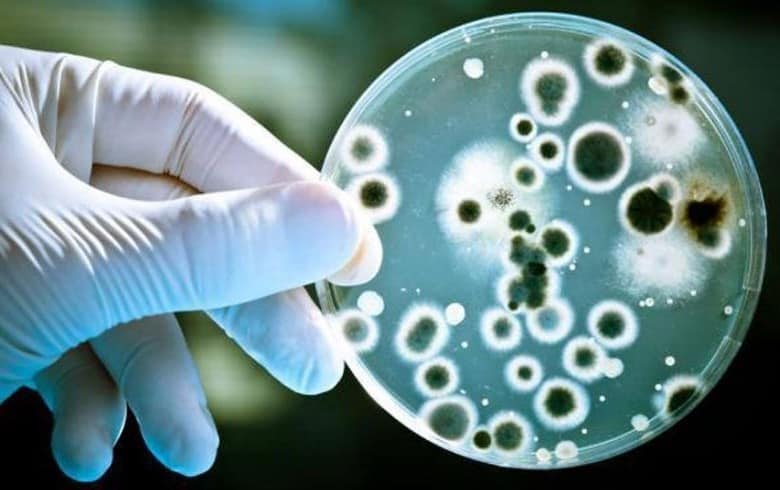
Avrupa’da antibiyotiğe direnç gösteren bakteri salgını korkutuyor!

Avrupa’da antibiyotiğe direnç gösteren bakteri salgını korkutuyor!
2 Bin Kişi Hayatını Kaybetmişti
Bu bakteri nedeniyle 2015 yılı içerisinde Avrupa’da 2 bin kişinin hayatını kaybettiği biliniyor. Bu bakterinin yol açtığı enfeksiyonun tedavisi ise neredeyse imkansız. Çünkü bakteri, birçok antibiyotiğe karşı direnç göstermektedir. Sanger Institute araştırmacıları tarafından yapılan açıklamaya göre bakterinin birçok antibiyotiğe karşı dirençli olması olağanüstü endişe verici bir durum.
Sağlıklı insanların bağırsaklarına yerleşerek hiçbir sağlık problemine yol açmadan doğal yaşayabilen bu bakteri, bağışıklık sistemi zayıf düşmediği takdirde hiçbir belirti vermiyor. Eğer bağışıklık sistemi zayıf düşerse ciğerlerde zatürre ve beyinde ise menenjit şeklinde ciddi sağlık problemlerine neden olabiliyor.
En Etkili Antibiyotiklere Direnç Gösteriyor
Sanger Institute’de görevli araştırmacı Dr. Sophia David, bu bakterinin dünyadaki en etkili antibiyotiklere karşı dahi dirençli olmasının korkunç bir tablo ortaya koyduğunu dile getirdi.
Bu bakterinin yol açtığı enfeksiyonun yüksek ölüm oranlarına neden olduğuna da değinen Dr. Sophia David, “Bu bakteri nedeniyle 2015 yılı içerisinde 2 bin kişi yaşamını yitirdi. Yeni tedbirler alınmadığı takdirde bu sayının ciddi oranda artması kaçınılmazdır.” dedi.



